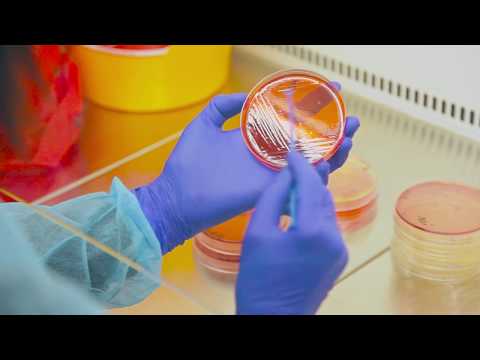
სურსათის კვლევა - ვიდეო-რგოლი

მცენარეთა მავნე ორგანიზმების დიაგნოსტიკა- ვიდეო-რგოლი
სსიპ სოფლის მეურნეობის სამინისტროს ლაბორატორია-ის სხვა ვიდეოები
 45:23
45:23
"ფერმერის საათი" 05 06 16
 01:58
01:58
24 07 2016 "ყველის ფესტივალი" ქ .მცხეთაში - ტვ პ...
 01:17
01:17
მცენარეთა მავნე ორგანიზმების დიაგნოსტიკა- ვიდეო-რგ...
01:02
01:02
სურსათის კვლევა - ვიდეო-რგოლი
 05:44
05:44
ქართული თაფლის გზა - ტვ garbonline.tv
 01:11
01:11
სემინარი ფუტკრისა და თევზის დაავადებებზე- ქ.ბათუმი
 01:23
01:23
ევროკომისარის ვიზიტი
 00:36
00:36
ტვ იმედი კონფერენცია 11 00 27 01 18

მსგავსი ვიდეოები

სსიპ სოფლის მეურნეობის სახელმწიფო ლაბორატორია - ვიდეორგოლი

მცენარეთა მავნე ორგანიზმების დიაგნოსტიკის ლაბორატორია გორში...
Tv Dia

მწვანე აფთიაქი
Bio Farmacy

ყველაზე შხამიანი და საშიში მცენარეები
ყველაზე საინტერესო არხი

Talk show (EU/PIN project) მაცნე - ფიტო-სანიტარიული სერთიფიკ...
Natia Montgomery FOOD TV

მინერალური ზეთი კოსმეტიკაში | არის თუ არა მინერალური ზეთი მა...
MSTAMRO

ორქიდეას ფოთლები რბილი და ჩამოშვებულია რა არი ამის მიზეზი
Lela Chitashvili

"ბიო-ბაქტერია" ინოვაცია ფერმერებისთვის!
AGRO TV